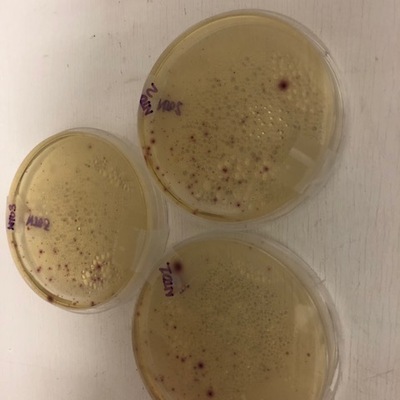
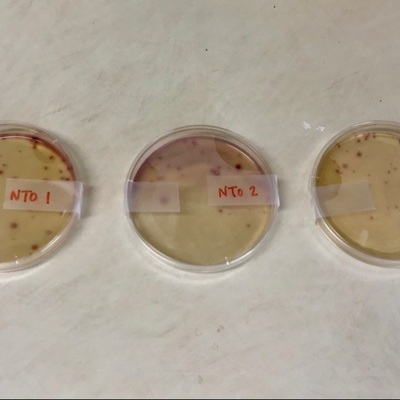
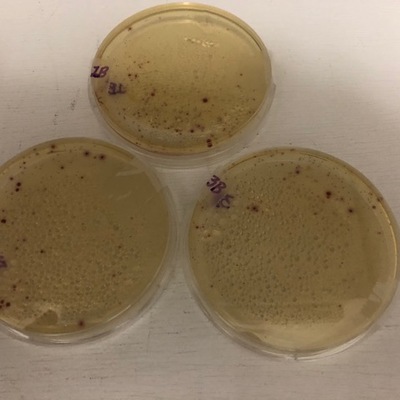
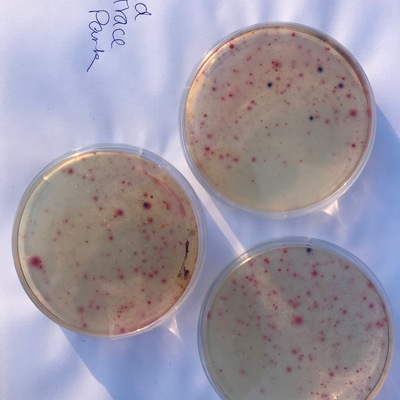

Location
Natchez Trace Overlook
Ross Barnett Reservoir
Ross Barnett Reservoir in Mississippi
Dataset summary
Natchez Trace Overlook has data for previous_weather, e_coli, other_coliform, air_temperature, total_coliform, incubation_time, water_temperature, incubation_temperature, current_weather, current_weather_description, previous_weather_description, river_stage, and flow from 28 April 2018 to 29 August 2024.
- Water body type Lake
- Dataset Mississippi Water Stewards, Mississippi State University
- Data collector Abby Braman
Data sharing
-
All datasets are open by default.
Download location data
This data is part of a bigger dataset, Mississippi Water Stewards.